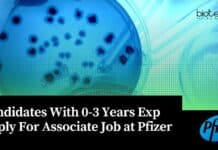
Candidates With 0-3 Years Exp Apply For Associate Job at Pfizer Microbiology Jobs Pfizer 2023

ICMR-NIOH JRF Job Opening – Attend Walk-In-Interview
ICMR-NIOH JRF Job Opening - Attend Walk-In-Interview
ICMR-NIOH JRF Job Opening - Attend Walk-In-Interview. MSc Life Sciences and Biological Sciences JRF Job. Interested and eligible...
Govt HPPSC Assistant Professor Recruitment 2022, Apply Online
Govt HPPSC Assistant Professor Recruitment 2022, Apply Online
Govt HPPSC Assistant Professor Recruitment 2022, Apply Online. Himachal Pradesh Public Service Commission Botany Assistant Professor Recruitment...
ICAR-IARI BTech Biotechnology JRF/ Project Associate-I Recruitment
ICAR-IARI BTech Biotechnology JRF/ Project Associate-I Recruitment
ICAR-IARI BTech Biotechnology JRF/ Project Associate-I Recruitment. IARI Jobs 2022. ICAR-IARI job opening. BTech Biotechnology JRF/ Project Associate-I...
NIMHANS Project Associate Job For MSc & BTech, Applications Invited
NIMHANS Job Opening 2022 - MSc & BTech Apply For Project Post
NIMHANS Job Opening 2022 - MSc & BTech Apply For Project Post. Project...
Project Fellow Recruitment at Bharathidasan University, Applications Invited
Project Fellow Recruitment at Bharathidasan University, Applications Invited
Project Fellow Recruitment at Bharathidasan University, Applications Invited. MSc & MPhil Biochemistry/Lifescience/Microbiology/Biotechnology job opening. Interested and eligible...
ICAR-NBPGR Project Scientist Job Opening – Attend Walk-In
ICAR-NBPGR Project Scientist Job Opening - Attend Walk-In
ICAR-NBPGR Project Scientist Job Opening - Attend Walk-In. MSc Bio-informatics/Molecular Biology/ Life Sciences/ Biotechnology Project Job. Interested...
Ferrero Process Technologist Job For Food Technology, Apply Online
Ferrero Process Technologist Job For Food Technology, Apply Online
Ferrero Process Technologist Job For Food Technology, Apply Online. BSc & MSc Food Technology Process Technologist...
CSIR-NEERI Biological Sciences Project Assistant Recruitment
CSIR-NEERI Biological Sciences Project Assistant Recruitment
CSIR-NEERI Biological Sciences Project Assistant Recruitment. BSc Biological Sciences project assistant job at CSIR-NEERI. CSIR - National Environmental Engineering...
NISER Biological Sciences Post-Doctoral Fellow Recruitment, Applications Invited
NISER Biological Sciences PDF Job, Applications Invited
NISER Biological Sciences PDF Job, Applications Invited. National Institute of Science Education and Research Bhubaneswar PDF Job. Interested...
ICAR-NDRI Research Fellow Recruitment – Attend Walk-In-Interview
ICAR-NDRI Research Fellow Recruitment - Attend Walk-In-Interview
ICAR-NDRI Research Fellow Recruitment - Attend Walk-In-Interview. Biotech, Molecular Biology, Microbiology, Life Sciences research job openings at ICAR...
20 Secrets To Score 99 Percentile in GATE 2023 Exam + Download FREE GATE...
How to Score 99 Percentile in GATE Exam + Download FREE Starter Kit
The Graduate Aptitude Test in Engineering (GATE) is a national examination that...
AcSIR CSIR-CFTRI PhD Admission 2022 August Session, Apply Online
AcSIR CSIR-CFTRI PhD 2022 Admission August Session, Apply Online
AcSIR CSIR-CFTRI PhD 2022 Admission August Session, Apply Online. Admission for Ph.D. programme of Academy of...
Biotecnika Times Newsletter 04.05.2022 Govt NIFTEM Job, CSIR-IGIB Hiring, Govt IASST
Biotecnika Times - Govt NIFTEM Job, CSIR-IGIB Hiring, Govt IASST
Govt Food Technology Jobs at NIFTEM-T With Rs. 60,000 pm Pay, Online Application Process
Food Technology...
How To Fix Your Broken Career? Listen To CEO Mr Shekhar Suman’s Tips
Biotecnika Career Guidance - How To Fix Your Broken Career?
Career is a word that always worries us. How do I grow in my career?...
Tips To Solve Previous Years Question Papers + FREE CSIR NET Mock Test Series
Tips To Solve PYQ Papers + FREE CSIR NET Mock Test Series
Previous Year's Question papers are such a tool which helps us succeed in...